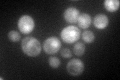

View description
Soluble fumarate reductase, required with isoenzyme Osm1p for anaerobic growth; may interact with ribosomes, based on co-purification experiments; authentic, non-tagged protein is detected in purified mitochondria in high-throughput studies
Localization:
Intensity:
Fold change:
Significance:
-
C’ GFP library in SD

cytosol107.74 -
N' NOP1pr-GFP in SD

N/A0 -
N' TEF2pr-mCherry in SD

N/A0 -
N' NATIVEpr-GFP in SD

N/A0 -
N' TEF2pr-VC and Cyto-VN in SD

N/A0 -
C’ GFP library in SD+DTT

cytosol170.781.58Yes -
C’ GFP library in SD+H2O2

cytosol124.421.15No -
C’ GFP library in Starvation Media
cytosol119.731.11No -
C’ GFP library on the background of Pup2-DaMP

N/A -
C’ GFP library on the background of CCT mutant

N/A0N/AYes
